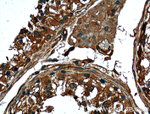
FKBPL Antibody in Immunohistochemistry (Paraffin) (IHC (P))

Search
Proteintech
FKBPL Monoclonal Antibody (2H10B10)
{{$productOrderCtrl.translations['antibody.pdp.commerceCard.promotion.promotions']}}
{{$productOrderCtrl.translations['antibody.pdp.commerceCard.promotion.viewpromo']}}
{{$productOrderCtrl.translations['antibody.pdp.commerceCard.promotion.promocode']}}: {{promo.promoCode}} {{promo.promoTitle}} {{promo.promoDescription}}. {{$productOrderCtrl.translations['antibody.pdp.commerceCard.promotion.learnmore']}}
产品信息
66389-1-IG
种属反应
宿主/亚型
分类
类型
克隆号
抗原
偶联物
形式
浓度
规格
纯化类型
保存液
内含物
保存条件
运输条件
产品详细信息
Immunogen sequence: ETPPVNTIG EKDTSQPQQE WEKNLRENLD SVIQIRQQPR DPPTETLELE VSPDPASQIL EHTQGAEKLV AELEGDSHKS HGSTSQMPEA LQASDLWYCP DGSFVKKIVI RGHGLDKPKL GSCCRVLALG FPFGSGPPEG WTELTMGVGP WREETWGELI EKCLESMCQG EEAELQLPGH SGPPVRLTLA SFTQGRDSWE LETSEKEALA REERARGTEL FRAGNPEGAA RCYGRAL (2-237 aa encoded by BC004168)
靶标信息
The protein encoded by this gene has similarity to the immunophilin protein family, which play a role in immunoregulation and basic cellular processes involving protein folding and trafficking. The encoded protein is thought to have a potential role in the induced radioresistance. Also it appears to have some involvement in the control of the cell cycle.
仅用于科研。不用于诊断过程。未经明确授权不得转售。
生物信息学
蛋白别名: FK506 binding protein like; FK506-binding protein 4; FK506-binding protein-like; FKBPL; immunophilin-like protein NG7; peptidyl-prolyl cis-trans isomerase; unnamed protein product; WAF-1/CIP1 stabilizing protein 39; WISp39
基因别名: DIR1; FKBPL; NG7; Ppiase-X; WISP39
UniProt ID: (Human) Q9UIM3, (Mouse) O35450, (Rat) Q6MG81
Entrez Gene ID: (Human) 63943, (Mouse) 56299, (Rat) 406168